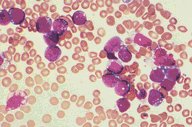

Description
This is a bone marrow smear from a patient with
acute leukemia. The blast cells are of medium
size and have basophilic cytoplasm which is
marked by the presence of several sharply
punched out vacuoles. The cells had no
differentiating features by immunopheno-typing or
cytochemistry and represent a case of acute
leukemia without differentiating features.
|
|
Click on this image
to enlarge it, then
on Back botton
in the Netscape Menu
to shrink it back down


|